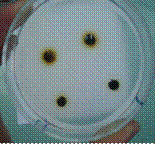
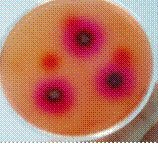
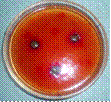

| Похожие рефераты | Скачать .docx | Скачать .pdf |
Дипломная работа: Разработка состава и технологии мазей мумиё на основе бентонитовых глин
Министерство образования и науки Республики Казахстан
Казахстанский фармацевтический институт
Кафедра химии и технологии фармацевтического производства
Фольмер Владимир Вильгельмович
Разработка состава и технологии мазей мумиё на основе бентонитовых глин
Специальность 390740 химия и технология фармацевтического производства
Караганды 2007
Министерство образования и науки Республики Казахстан
Казахстанский фармацевтический институт
Кафедра химии и технологии фармацевтического производства с курсом физико-математических дисциплин
Допущен к защите
"12 " июня 2007 г
Зав. кафедрой,
д. фарм. н., профессор
Абдуллабекова Р.М.
ДИПЛОМНАЯ РАБОТА
Разработка состава и технологии мазей мумиё на основе бентонитовых глин
Студент: ХТ - 501
Фольмер В.В.
Научный руководитель:
Гизатуллина Д.Р.
КАЗАХСТАНСКИЙ ФАРМАЦЕВТИЧЕСКИЙ ИНСТИТУТ
(наименование вуза)
Факультет Химия и технология фармацевтического производства
Специальность 390740 химия и технология фармацевтического производства
Кафедра химии и технологии фармацевтического производства с курсом физико-математических дисциплин
ЗАДАНИЕ
на выполнение дипломного проекта (работы)
Студенту Фольмеру Владимиру Вильгельмовичу
Тема работы: "Разработка состава и технологии мазей мумиё на основе бентонитовых глин"
Утверждена приказом по вузу № 91/уч. от "31" августа 2006
Срок сдачи законченного проекта (работы)"12" июня 2007 года
Исходные данные к проекту (работе):
Технологически доступное сырье - мумиё и бентонитовые глины.
Перечень подлежащих разработке в дипломном проекте вопросов или краткое содержание дипломной работы:
а) провести анализ литературных данных и обосновать выбор предложенных веществ в качестве компонентов мази;
б) подобрать состав мазей мумие на основе бентонитовых глин;
в) провести биофармацевтические исследования полученных мазей мумие на основе бентонитовых глин;
г) провести оценку качества полученной мази мумие на основе бентонитовой глины
Перечень графического материала (с точным указанием обязательных чертежей)
Технологическая схема получения мази, таблицы с подобранным составом мазей мумие, графики зависимости высвобождения действующего вещества от состава основы.
Рекомендуемая основная литература:
Марченко Л.Д., Русак А.В., Смехова И.Е. Технология мягких лекарственных форм. Санкт - Петербург. - 2004 г.
Чуешов В.И. Промышленная технология лекарств. В 2 - х томах. Изд-во: НФАУ МТК - Книга - Харьков - 2002 г.
Сало Д.П., Овчаренко Ф.Д., Круглицкий Н.Н. Высокодисперсные минералы в фармации и медицине, "Наукова думка", Киев - 1969 г.
Мусоев С.М., Хайдаров К.Х. Исупов С.Д., Исследование репаративной активности мумие. Научная конференция, посвященная 50-летию Института химии имени В.Н. Никитина АН Республики Таджикистан: Материалы - Душанбе 1996, - Т.39, № 1 - 2
Байзолданов Т., Даткаев У.М., Устенова Г.О. Учебно-методическое пособие по спецкурсу "Биофармация, Алматы. - 2005
Консультации по проекту (работе) с указанием относящихся к ним разделов проекта (работы)
| Раздел | Консультант | Сроки | Подпись |
| 1. Технология получения мазей | Гизатуллина Д.Р. | Февраль | |
| 2. Биофармацевтические исследования полученных мазей | Гизатуллина Д.Р. | Март | |
| 3. Оценка качества мазей | Гизатуллина Д.Р. | Апрель | |
| 4. Оформление дипломного проекта (работы) | Гизатуллина Д.Р. | Май - июнь |
График подготовки дипломного проекта (работы)
| № п/п | Наименование раздела, перечень разрабатываемых вопросов |
Сроки предоставления руководителю | Приме-чание |
| 1 | Подготовка обзора литературы | 20.02.07 | |
| 2 | Изучение технологии мазей | 25.02.07 | |
| 3 | Подбор основ для мазей | 28.02.07 | |
| 4 | Изучение методик определения биологической доступности мазей | 07.03.07 | |
| 5 | Определение биодоступности мазей мумие на основе бентонитовых глин методом диффузии в агар | 30.03.07 | |
| 6 | Определение стабильности мазей мумие на основе бентонитовых глин | 13.04.07 | |
| 7 | Оформление дипломного проекта (работы) | 30.05.07 | |
| 8 | Апробация дипломного проекта (работы) | 04.06.07 | |
| 9 | Защита дипломного проекта (работы) | 03.07.07 |
Дата выдачи задания 8 февраля 2007 г.
Заведующий кафедрой ___________________ Абдуллабекова Р.М.
(подпись)
Руководитель проекта _______________________Гизатуллина Д.Р.
(подпись)
Задание принял к исполнению студент __________Фольмер В.В.
(подпись)
Содержание
Условные обозначения и сокращения
Введение
1. Современные проблемы создание мягких лекарственных форм
1.1 Состояние и перспективы развития технологии мазей
1.2 Применение бентонитовых глин в медицине и фармации
1.3 Использование мумие в медицине
2. Материалы и методы исследования
2.1 Материалы исследования
2.2 Методы исследования
3. Технология мазей мумие на основе бентонитовой глины
3.1 Разработка состава мазей мумие на основе бентонитовой глины
3.2 Технология мази "Бенто М"
Заключение
Список использованных источников
Условные обозначения и сокращения
АБ - антибиотики
БГ - бентонитовая глина
КМЦ - карбоксиметилцеллюлозу
- контроль микробиологический
- контроль технологический
- контроль химический
ЛВ - лекарственные вещества
ЛФ - лекарственная форма
МЦ - метилцеллюлоза
об/мин - оборотов в минуту
ПАВ - поверхностно активные вещества
ПВС- поливиниловый спирт
ПЭГ- полиэтиленгликоль
ПЭО - полиэтиленоксид
РК - республика Казахстан
СНГ - содружество независимых государств
ТП - получение мази мумиё на основе бентонитовой глины
УМО - фасовка мази мумиё на основе бентонитовой глины
ТУ - технические условия
Введение
Актуальность темы. Одной из первоочередных задач Министерства здравоохранения РК является обеспечение населения и лечебно-профилактических учреждений страны эффективными и экономически доступными лекарственными препаратами. В концепции реформы системы здравоохранения, утвержденной Постановлением Правительства РК, одним из приоритетных направлений реформирования фармацевтического сектора страны является улучшение экономической доступности лекарственных средств посредством развития отечественной фармацевтической промышленности и разработки лекарственных средств на основе местного лекарственного сырья. В настоящее время лекарственные препараты в основном экспортируют из стран дальнего и ближнего зарубежья, а также из местного сырья производится незначительное количество лекарственных средств (около 25%). Сложившаяся ситуация влияет на себестоимость лекарственных средств, что значительно ограничивает их использование населением.
Одним из путей вывода из лекарственного кризиса является эффективное использование местного сырья для разработки и внедрения в медицинскую практику новых лекарственных средств.
Республика Казахстан располагает большими ресурсами природного лекарственного сырья: минералов (бентонит, мумие, каменная поваренная соль), сырье животного (яды змей и пчел) и растительного происхождения. Кроме того, научно-исследовательскими институтами страны синтезируются десятки новых биологически активных веществ.
Мумие известно в восточной медицине более 3000 лет. Его применяли в своей практике средневековые ученые Востока - Ибн Сино, Бируни, Рози, Мухаммед Табиб, Мухаммед Арзани и многие другие. Однако, оно стало объектом исследования современной медицины только в последние 35-45 лет (Шакиров, 1967, 1983; Нуралиев Ю.Н., 1977, 1993; Корчубеков Б.К., 1993; Фролова Л.Н., 1999).
Бентонитовые глины в фармацевтической технологии применяются при производстве мазей, таблеток, в качестве адсорбента для очистки белков, ферментов, а также для стабилизации суспензий и ряда физиологически активных субстанций, таких как простагландины и фосфолипиды (Сало Д.П. и др., 1969г), (Цагарейшвили Г.В., 1974 г.; Кариев А.Р., 2001г).
Несмотря на проведенные многочисленные исследования вышеуказанных объектов, до сих пор, отсутствуют рациональные лекарственные формы на их основе.
Поэтому, разработка высокоэффективных и недорогостоящих лекарственных форм на основе бентонита, мумие, является одной из актуальных проблем современной фармацевтической науки.
Цели и задачи исследования. Цель настоящего исследования - разработка научно обоснованных состава и технологии мазей мумиё на основе бентонитовых глин Республики Казахстан.
Для достижения поставленной цели необходимо решить следующие задачи:
Разработать состав мази мумие на основе бентонитовой глины;
Провести биофармацевтические исследования полученной мази мумие на основе бентонитовой глины;
Провести оценку качества полученной мази мумие на основе бентонитовой глины.
Научная новизна работы. Впервые изучена и использована бентонитовая глина в качестве основы для мази мумие.
1. Современные проблемы создание мягких лекарственных форм
1.1 Состояние и перспективы развития технологии мазей
Мазь - мягкая ЛФ, предназначенная для нанесения на кожу, раны или слизистые оболочки. Мази состоят из основы и одного или нескольких лекарственных веществ, равномерно в ней распределенных. В состав мазей входят стабилизаторы, консерванты [1].
Мази широко применяются в различных областях медицины: при лечении дерматологических заболеваний, в отоларингологии, в хирургической, проктологической, гинекологической практике, а также как средство защиты кожи от неблагоприятных внешних воздействий (органические вещества, кислоты, щелочи).
В последнее время мази применяются и для воздействия на внутренние органы, и весь организм, с целью лечения, профилактики и диагностики заболеваний.
Основы для мазей. Основы обеспечивают необходимую массу мази и, таким образом, надлежащую концентрацию лекарственных веществ, мягкую консистенцию, оказывают существенное влияние на стабильность мази. Степень высвобождения ЛВ из мази, скорость и полнота их резорбции во многом зависят от природы и свойств основы.
А) мягкая консистенция необходима для удобства нанесения на кожу и слизистые оболочки.
Б) химическая инертность основ гарантирует отсутствие взаимодействия с лекарственными веществами, изменения под действием внешних факторов (воздух, свет, влага, температура), следовательно, обеспечивает стабильность мази.
В) отсутствие аллергических раздражителей и сенсибилизирующего действия мази зависит от безвредности биологических основ.
Г) важно, чтобы основы не нарушали физических функций кожи. Наружный слой кожи обладает кислой реакцией, которая препятствует размножению микроорганизмов, поэтому сохранение первоначального значения рН кожи имеет большое значение.
Д) присутствие микроорганизмов может быть причиной повторного инфицирования воспаленной кожи и слизистой, а также снижения активности лекарственных веществ.
Е) большое значение имеет вопрос о легкости удаления остатков мази с белья, поверхности кожи, особенно с их волокнистых участков.
Ж) свойства основы должны соответствовать цели назначения мази.
Основы для поверхностно действующих мазей не должны способствовать глубине всасывания лекарственных веществ. Основы для мазей резорбтивного действия, наоборот, для обеспечения всасывания лекарственных веществ через слой кожи. Основы защитных мазей должны быстро высыхать, и плотно прилегать к поверхности кожи. Известно несколько классификаций основ для мазей. По физическим свойствам, по химическому составу, источнику получения и т.д.
Наиболее целесообразной является классификация по степени родства свойств лекарственных веществ и основ, по возможности растворения лекарственных веществ в основе.
В соответствии с этим принципом, все мазевые основы делят на 3 группы: липофильные, гидрофильные и липофильно-гидрофильные основы.
Главная задача технологии при изготовлении мази состоит в том, чтобы лекарственные вещества были максимально диспергированы и равномерно распределены по всей массе основы, консистенция мази обеспечивала бы легкость нанесения и равномерное распределение по коже или слизистой оболочке; стабильность мази гарантировала бы неизменность ее состава при ее применении и хранении. Подготовка основы для мазей. Основу расплавляют в бочке или баке "шаре" и перемещают в варочный котел. Если несколько компонентов, плавятся, начиная с тугоплавких веществ. При необходимости фильтруют основу через холст или марлю. Лекарственное вещество измельчают просеиванием через сито.
Введение лекарственных веществ в основу представлено на рисунке 1.
![]() |
Рисунок 1 - Введение лекарственных веществ в основу
Добавление ЛВ к основе осуществляется в 2 вальцовых смесителях или в реакторах с паровой рубашкой, или электрическим обогревом, снабженным тремя мощными мешалками: якорной, лопастной, турбинной, обеспечивающей хорошее перемешивание и перетирание компонентов мази. Схема введения лекарственных веществ В зависимости от способа введения лекарственных веществ и характера распределения их в основе, мази классифицируются: гомогенные, суспензионные, эмульсионные и комбинированные.
Гомогенные: мази-сплавы (сочетание 2 или нескольких взаиморастворимых компонентов) и мази-растворы (содержащие лекарственные вещества, растворенные в основе), приготовление мазей начинают с плавления основы, после чего в полученном расплаве растворяют лекарственные вещества.
Суспензионные - мази, содержащие лекарственные вещества, нерастворимые в воде и основе, распределяемые в ней по типу суспензии.
Эмульсионные - характеризуются наличием жидкой дисперсионной фазы, нерастворимой в основе, и распределенной в ней по типу эмульсии (дисперсионная фаза - Н2 О2 , линетол, глицерин, деготь, жидкость Бурова, а также растворы лекарственных веществ).
Комбинированные - наиболее сложные многокомпонентные системы, содержащие жидкость и твердые ингредиенты, один из которых растворяется в воде, другой в основе, третий - ни там, ни там.
Гомогенизация мазей - если при перемешивании не удается получить необходимую степень дисперсности лекарственных веществ, осуществляется в жерновых мельницах, либо в валковых мазетерках, а также аппаратах РПА.
Стандартизация - мазь стандартизируют по содержанию лекарственных веществ, значению рН и степени дисперсности твердых частиц в суспензионной мази.
Фасовка и хранение - в стеклянные банки, полиэтиленовые и алюминиевые тубы. Упаковка в тубы с помощью тубонабивочных автоматов. Хранят мази в прохладном, защищенном от света месте. Изготовленную в аптеке мазь хранят 10 суток.
Основные направления совершенствования качества и технологии мазей.
Расширение ассортимента мазевых основ и их выбор в зависимости от применения мази и возраста больного.
Повышение физической устойчивости суспензионных и эмульсионных мазей может быть достигнуто добавлением загустителей, эмульгаторов и др. вспомогательных веществ.
Химическая стабильность - применение антиоксидантов (бутилоксианизол, α-токоферол и др.).
Микробиологическая стабильность - с помощью консервантов (кислота сорбиновая 0,2%, смесь 1: 3 нипагина и напизола, спирт бензиловый 0,9%).
Проблема упаковки - в связи с современными требованиями к уровню микробной контаминации в нестерильных лекарственных средствах. Создаются комбинированные (ламинированные) материалы, сочетаются лучшие свойства алюминиевой фольги, полимеров, бумаги. Создаются упаковки одноразового пользования [2].
Основы для мазей (носители лекарственных веществ) придают мази определенный объем, консистенцию, обеспечивают определенную концентрацию лекарственных веществ. От удачного сочетания лекарственных веществ и компонентов основы зависит скорость высвобождения лекарственных веществ и, следовательно, фармакологический эффект.
В настоящее время в мировой медицинской практике применяют значительное количество различных основ для мазей. Для применения в медицине могут быть разрешены основы, которые отвечают определенным требованиям, современная основа должна:
Обеспечивать проявление специфической активности мази;
Не нарушать физиологических функций кожи, не вызывать аллергических реакций, не оказывать токсического, раздражающего, сенсибилизирующего действия на организм;
Быть химически индифферентной, не взаимодействовать с лекарственными веществами, не изменяться под действием факторов внешней среды (света, кислорода, влаги);
Обеспечивать необходимую консистенцию, оптимальные реологические свойства (способность легко намазываться на кожу или слизистые оболочки, не подвергаться расслаиванию, легко выдавливаться из туб);
Легко смешиваться с лекарственными веществами и высвобождать их при контакте с кожей и слизистыми оболочками;
Не подвергаться микробной контаминации;
Быть доступной и экономически целесообразной, иметь хороший товарный вид.
Идеальной основы до настоящего времени не существует. Многообразие основ, применяемых в мировой фармацевтической практике, требует их классификации. В ГФ в основу классификации положен наиболее характерный признак - сродство основы к воде, полярным или неполярным веществам. Если известны физико-химические свойства веществ, это позволяет выбрать оптимальный способ введения их в основу мази [3].
Основы классифицируют, выделяя липофильные, гидрофильные и липофильно-гидрофильные, или гидрофильно-липофильные (дифильные) основы - абсорбционные; эмульсионные (типов "масло в воде", "вода в масле" и смешанного типа).
Гидрофильные основы. Гели белков. Представлены желатино-глицериновыми гелями, коллагеновыми основами.
Желатиноглицериновые гели содержат от 1 до 3% желатина, до 30% глицерина; 70-80% воды очищенной. В косметических мазах содержание желатина не должно превышать 3%.
Гели коллагена . В последние годы в России и других странах проводятся исследования в целях получения основ для мазей, содержащих коллаген - биополимер, набухающий в воде.
Коллагеновые основы в виде 3-5% гелей рекомендованы для мазей с веществами, обладающими ранозаживляющим действием, с анестетическими, антисептическими: 3% гели имеют оптимальные реологические свойства, легко наносятся на кожу; 5% гели- более плотные массы. В коллагеновые основы можно вводить до 3% стрептоцида, 3-5% борной кислоты, и другие лекарственные вещества.
Гели полисахаридов . Для изготовления основ этой группы наиболее широко применяют производные целлюлозы: метилцеллюлозу, натрий-карбоксиметилцеллюлозу.
Гели эфиров целлюлозы представляют собой порошки или волокнистые массы без запаха и вкуса. В фармацевтической практике применяют 3-8% гелей МЦ (3% гель для изготовления мазей глазных) и 4-6% гели Na-КМЦ. Гели эфиров целлюлозы - вязкие, структурированные, прозрачные, без запаха, хорошо высвобождают лекарственные вещества, обеспечивают резорбцию, биологически безвредны.
Крахмально-глицериновые гели представляют собой 7% раствор крахмала в глицерине и носят название глицериновой мази.
Гели полисахаридов микробного происхождения также используются как основы для мазей.
Гели агара . Включены в ГФ в качестве основы для мазей. Агароид получают из водорослей, это достаточно дорогой продукт. Он представляет собой тонкие прозрачные пластинки. В качестве основы применяют 1,5% водно-глицериновые гели, которые изготавливают также, как желатино-глицериновые. Применяют в основном при изготовлении косметических кремов.
Гели фитостерина . Фитостерин получают при щелочном гидролизе сосновой древесины. Основной компонент фитостерина β-ситостерин (по строению близок к холестерину).
Гели глинистых минералов (бентонитовых глин). Бентонитовые глины имеют сложный состав. Это алюмогидросиликаты, полимеры неорганической природы. Содержат примеси оксидов кальция, натрия, калия, магния, титана, воду; алюминий может быть частично замещен железом и магнием.
Гели синтетических высококомпонентных соединений . Гели полиэтиленоксидов (ПЭО) или полиэтиленгликолей (ПЭГ).
Гели поливинилового спирта. Поливиниловый спирт - порошок или крупинки белого или слегка желтоватого цвета, нерастворимые в этаноле, в воде, в глицерине, ПВС растворим при нагревании. Водные растворы ПВС обладают высокой вязкостью. Применяют гели 10-15% концентрации, они предложены для изготовления ксероформной, левомицетиновой, камфорной, анестезиновой и других мазей.
Гели поливинилпирролидона . Поливинилпирролидон - бесцветный, прозрачный, аморфный, гигроскопичный порошок, растворимый в воде, глицерине, ПЭО, хлороформе. Водные растворы при длительном хранении изменяют цвет, подвергаются микробной контаминации, поэтому в их состав вводят консерванты.
Гели сополимеров акриловой кислоты . В современной медицине и косметике все более широкое применение получают линейные сшитые сополимеры акриловой кислоты.
1.2 Применение бентонитовых глин в медицине и фармации
Бентонитовыми глинами принято называть, независимо от генезиса, тонкодисперсные глины, состоящие не менее чем на 60-70% из минералов группы монтмориллонита (Al2 O3 ∙4SiO2 ∙H2 O), обладающих связующей способностью, адсорбционной и каталитической активностью и проявляющие упруго-пластично-вязкие свойства даже в разбавленных суспензиях. Если преобладающим компонентом является монтмориллонит, но его содержание меньше 60%, их принято называть бентонитоподобными [4].
В настоящее время БГ обнаружены в США, Канаде, Западной Германии, Франции, Японии, Северной и Южной Африке, Италии, Индии, Венгрии, Чехословакии, Китае, а из стран СНГ - Грузии, Азербайджане, Армении, России, Украине, Казахстане, Узбекистане, Таджикистане [5].
Бентонит в народной медицине Востока издавна применяется в качестве детской присыпки, адсорбирующего и ранозаживляющего средства. Сведения о лечебном значении БГ имеются в трудах Абу Али ибн Сино. Еще Гален знал, что при добавлении глин в лекарства бентониты смягчали и удлиняли действие последних, как бы разбавляли их. Народная медицина Тибета использовала глину для изготовления лепешек - аппликации на больные места, в качестве компрессов. В Германии в клинических условиях глинами успешно лечат острые респираторные заболевания, бронхиты, плевриты, перитониты, желчнокаменную болезнь и заболевания мочевого пузыря. Бентониты адсорбируют токсичные вещества и могут служить противоядием при отравлениях, как эффективное антигельминтное средство, могут входить в состав антигена, вводимого в живые существа. Способность БГ к селективной адсорбции химических веществ играет значительную роль при лечении болезней желудочно-кишечного тракта. Клиническими испытаниями установлено, что препарат, обогащенный магнием аскангеля, является эффективным средством для лечения ряда желудочно-кишечных заболеваний и функциональных расстройств. Препарат показан при таких заболеваниях, как хронический гастрит с секреторной недостаточностью, хронический небактериальный колит, хроническая дизентерия, метеоризм различного происхождения. Следует заострить внимание на эффективности магний аскангеля при метеоризме, возникшем на фоне инфаркта миокарда. Кроме того, согласно проведенным исследованиям, выполненным на кафедре гастроэнтерологии Крымского медицинского института, применение бентонита при лечении некоторых заболеваний органов пищеварения оказалось успешным. У больных с патологией желудка и кишечника положительное влияние отмечено на первой неделе лечения, у большинства больных в виде уменьшения интенсивности болевого синдрома, метеоризма и пр. Грузинские ученые сообщают о возможности применения раствора бентонита (асканколл) при опрелостях у детей, в случаях эрозии шейки матки, в хирургической и урологической практике. На основании проведенных клинических испытаний, они пришли к заключению, что в лечении пиодермии и мацерации кожи, как осложнений после ранений, применение асканколла с профилактической целью дает хороший результат. Также изучено вяжущее и адсорбирующее действие грузинского бентонита, и установлено, что при его применении в количестве 2,0г у больных отмечается заметное улучшение кишечных явлений. Американские ученые также сообщают об эффективности бентонита при лечении желудочно-кишечного дискомфорта. Они также подтверждают, что бентонит выделяется из организма без оказания какого-либо токсического действия. Доказана эффективность комплексной терапии больных нейродермитом с использованием даларгина, бентонитов, торфопасты и рутинных препаратов и установлено, что применение бентонита значительно снижает материальные затраты и делает метод лечения более доступным. Ряд авторов сообщает об эффективности лекарственных препаратов, содержащих бентонит, при лечении дерматитов. БГ, вместе с мумие и прополисом, рекомендуются при лечении болезней пародонта. Рекомендуется использование бентонита в качестве адсорбента при отравлении пестицидами, в частности при отравлении паракватом (Paraquat). В литературе имеются сведения о способности бентонитов адсорбировать афлотоксин и снижать его токсический эффект у подопытных животных.
По данным Н.Е. Берента, грамицидин-бентонитовый порошок очень эффективен при лечении больных эпидермофитией, и не оказывает никакого раздражающего действия на кожу, даже аллергизированную, с явлениями экзематизации. Кроме того, грамицидин-бентонитовая паста может использоваться как профилактическое и лечебное средство против лучевых поражений кожи.
Доказано, что бентонит можно использовать в качестве среды для ускоренной индикации иерсиний и предлагаемый авторами способ выделения иерсиний является более чувствительным, быстрым и экономичным по сравнению с известным способом. Кроме того, установлена возможность использования БГ в качестве сырья для приготовления питательных сред при культивировании кишечных бактерий. Получены доказательства высокой эффективности бентонитовых сред при выделении шигелл, сальмонелл и иерсиний из материала от людей, животных и объектов внешней среды. Применение этих сред позволяет увеличить число положительных находок на 50% для сальмонелл и на 30,6% для иерсиний, по сравнению с общепринятыми средами (магниевой и ФСБ).
По данным авторов, применение бентонита, взамен дефицитных реактивов, для концентрации и очистки ротавирусов оказалось простым и доступным методом, который можно эффективно использовать для решения ряда теоретических и практических вопросов, связанных с получением концентрированных и очищенных препаратов ротавирусов. В литературе также имеются сведения об использовании бентонитов для изоляции вируса гепатита А и энтеровирусов из воды.
Высокая дисперсность, гидрофильность, ярко выраженные коллоидные, эмульгирующие и многие другие ценные свойства щелочных бентонитов обусловливают возможность их широкого использования в фармацевтической технологии.
Об использовании БГ указано в Фармакопеях многих стран, например, США, Австралии, Бельгии, Чехии, Франции, Германии, Италии, Нидерландах, Португалии, Швейцарии, Индии, и др. [6]. В государственной Фармакопее Х-ХI изданий (выпуск 2) в общей статье "мази" имеется упоминание о возможности использования бентонитовой глины в качестве мазевой основы. В международной Фармакопее III издания также имеется статья "Bentonitum".
В настоящее время БГ широко применяются в фармации при изготовлении пилюль, гранулированных лекарств, таблеток, эмульсий, мазей, линиментов, а также для стабилизации суспензий. Согласно данным литературы, не все формы бентонитов могут быть использованы при изготовлении пилюль. По данным Д.П. Сало с соавт. Кальциевые и природные формы бентонитов придают пилюльной массе лучшую пластичность, эластичность и распадаемость.Д.К. Бахромов и др. считают целесообразным использование композиции адсорбентов, получаемых из местных глин Узбекистана для облагораживания липофильных суппозиторных основ. Ими доказано, что композиция аскомарского бентонита с Шер-Суйским по 0,5% и аскомарского бентонита с опоковидной глиной Кармине улучшили физико-химические показатели после облагораживания.
Бентонит также может быть использован в оральных фармацевтических препаратах, косметике и пищевых продуктах. Аналогично другим подобным силиконовым глинам, бентонит может быть использован для адсорбции катионитных лекарств с целью замедления их высвобождения. Было исследовано применение бентонита в качестве диагностирующего агента для магнитного резонансного представления.
Многочисленными авторами доказано, что бентонит обеспечивает гранулам активированного угля нужные терапевтические и технологические качества.
В литературе имеются сведения о том, что БГ обладают высокой склеивающей и разрыхляющей способностью и могут быть использованы при изготовлении гранул и таблеток.
Наряду с биологически активными свойствами, немаловажной является роль БГ как вспомогательных веществ в производстве таблетированных лекарственных форм. Они вводятся в таблетки с целью разбавления, разрыхления, склеивания, окрашивания, а также для придания таблеткам скользящих свойств и пролонгированного действия.
Первыми исследователями, обратившими внимание на БГ как на склеивающий и разрыхляющий агент, были С.В. Гранберг и Б.Е. Бентон. На примере приготовления таблеток тиреоидина они показали, что бентонит по своей склеивающей и разрыхляющей способности не уступает крахмалу и может быть с успехом применен для этих целей.
Возможность замены крахмала и других вспомогательных веществ Бентонитовыми глинами доказана и рядом других исследователей.
Ряд авторов сообщает об использовании глинистых материалов в качестве эмульгаторов в фармацевтических эмульсиях.
Согласно данным литературы, эмульгирующая способность глинистых минералов обусловлена природой обменного катиона, а также их кристаллической структурой. Это дает возможность с помощью ионного обмена получать глинистые минералы, обладающие той или иной эмульгирующей способностью.
Натриевые формы образуют в первое время стойкие высокодисперсные эмульсии, которые, при любой концентрации эмульгатора, остаются стабильны в течение одного месяца хранения, а затем расслаиваются. Однако, устойчивость таких эмульсий может быть увеличена прибавлением небольших количеств олеиновой кислоты (олеата натрия) или эмульгаторов противоположного типа, являющихся поверхностно-активными веществами.
Первым применил бентонит в качестве мазевой основы в 1924 году П.С. Броун.Б. Фантус и Х.А. Диневич в 1938 году сообщили об использовании ими бентонита для приготовления косметической пасты для лица, а Грифон успешно применил его для изготовления гидрофильных мазевых основ.
В 1943 году Н.А. Пастовский сообщил о применении бентонита для приготовления мазей со стрептоцидом и альбуцидом для лечения длительно незаживающих ран [7].
В 1944 году А.П. Терентьев сообщил об использовании бентонита при приготовлении мазей с целью лечения гнойных ран, стрептококковых дерматитов и потливости. Мазь на бентонитовой основе адсорбирует выделения из раны, устраняет их неприятных запах, защищает рану от пыли, не нарушая газообмен кожи.
О положительном эффекте дегтярной мази, в которой каменноугольный деготь эмульгировался с помощью бентонита, сообщал Д.М. Скауер.
Д.П. Сало рекомендует в приготовлении мазей на основе бентонита использовать его натриевые формы, вследствие того, что кальциевые формы быстрее высыхают.
В литературе приводятся данные о необходимости замены одной формы бентонита на другую. В частности, Na бентониты замещают Н бентонитом. В таких мазевых основах, в которых должны быть обработаны лекарственные вещества антисептического действия. Г.В. Цагарейшвили, используя способность бентонита высыхать, превращаться в порошок и при добавлении воды снова давать пластичную массу, применил грузинский бентонит (асканколл) как основу для приготовления сухих мазей ксероформа, дерматола и борной кислоты.
К. Брэиляну с соавт. разработали прополисную мазь с бентонитом, которая применяется при кожных заболеваниях. О разработке защитных паст с гидрофобным фенольным препаратом прополиса на бентонитовой основе, также сообщает А.И. Тихонов и др.
Георгидзе сообщает о целесообразности использования бентонита вместо вазелина в мази "Календула". Х.А. Хамидовой с соавт. разработаны составы и технологии мазей с некоторыми антибиотиками на основе БГ, в качестве мазевой основы. С.М. Мусоевым с соавт. разработан состав и технология мазей с липидным комплексом гриба FusariumSambucinumD. на основе бентонита.
Ряд авторов сообщают, что мази с салициловой и борной кислотами, стрептоцидом и некоторыми бактерицидными веществами, на бентонитовой основе, при клиническом испытании показали лучшие результаты, чем мази, приготовленные с этими веществами на свином жиру или вазелине с ланолином.
Работами Х.Р. Ходжаева и др. показано, что мазь нистатина на основе Тиха-аскане успешно можно использовать для лечения кандидозов кожи и слизистых. Результаты проведенных ими микробиологических исследований свидетельствуют о том, что из водного геля Тиха-аскане происходит полное высвобождение антибиотика нистатина.
Работами Казахстанских ученых доказано, что многокомпонентные многокомпонентные мази, содержащие левомицетин и метилурацил, а также метронидазол со стрептоцидом, изготовленные на бентонитовой основе, проявляют высокую антимикробную активность [8,9]. По данным литературы, введение 10% бентонита в линимент бальзамический Вишневского улучшает его реологические характеристики.
Согласно данным работ таджикских ученых, мази фурациллина и стрептоцида, изготовленные на бентонитовой основе, обладают более высокой антимикробной активностью, чем мази на вазелиновой основе [10,11]. Бентонит входит в состав лекарственного препарата Каломин, который обладает мягким вяжущим и противозудным эффектом.
В последние годы БГ широко применяются в фармацевтической практике для стабилизации суспензий.
Благодаря своей индифферентности, набухаемости, способности образовывать гели достаточной вязкости в небольших концентрациях (3-5%) и при высыхании образовывать на теле тонкие пропускающие воздух пленки, бентониты выгодно отличаются от других веществ, применяющихся для этих целей.
По данным А. Затурецкого [12], чехословацкий бентонит используется в качестве стабилизатора суспензии сернокислого бария для рентгенодиагностики желудка и стабилизатора жидких присыпок, содержащих растительный или каменноугольный деготь.
Kimpara с соавт. сообщали о стабилизирующем влиянии бентонита на суспензии дексаметазона. Исследования, проведенные Д.П. Сало и Чиргиным, показали, что 5% -ную суспензию украинских бентонитов можно с успехом применять для стабилизации суспензий, содержащих по 12,5% окиси цинка, талька и крахмала, используемых при лечении кожных и венерических болезней [13].
G. E. Forteza с соавт. показали, что под влиянием бентонитов повышается стабильность суспензии ряда антисептиков. По мнению А.С. Лехан и Д.П. Сало, лучшим стабилизатором суспензии для наружного применения является триэтаноламинобентонит, который придает им высокую стабильность [14]. Изучено адсорбционное и десорбционное свойство БГ Таджикистана в отношении эфирных масел иссопа зеравшанского, душицы и герани. Установлено, что вышеуказанные эфирные масла, адсорбированные Бентонитовыми глинами, не теряют своей антимикробной активности [15].
Согласно данным литературы, бентониты способны адсорбировать некоторые микроорганизмы и токсические вещества. Используя данные свойства бентонитов, венгерские ученые запатентовали состав суспензии, содержащей 40-50% бентонита, которая применяется как противоядное средство. Из литературы известно, что еще в древности бентонит, смоченный водой, использовался при воспалительных процессах, а в смеси с водой и глицерином - при легочных и ревматических заболеваниях, проявлениях золотухи, экземы, для очистки и заживления ран, а также в качестве лечебного и профилактического средства при опрелостях, для лечения эрозии шейки матки, как вяжущее средство при расстройствах желудочно-кишечного тракта, для лечения потливости стоп [5]. Несмотря на широкое использование бентонитов в качестве вспомогательных веществ, в литературе имеются данные о некоторых ограничениях для их применения, поскольку, обладая большой удельной поверхностью, они безвозвратно адсорбируют некоторые лекарственные вещества, иные дезактивируют либо щелочной реакцией своих гидрозолей и гидрогелей, либо ионообменными реакциями и т.д. [12].
Анализ литературы по бентонитовым глинам стран СНГ говорит о разнообразии минералогического состава и структурных особенностях, о разнообразии их физико-химических и технологических свойств, о широком использовании их в народном хозяйстве и фармацевтической промышленности.
1.3 Использование мумие в медицине
Мумие, как лекарственное средство известно в восточной медицине более трех тысяч лет. Еще Аристотель (4 век до н. э) описал лечебные свойства мумие, а также указал, как проверяются качество и лечебные свойства препарата. Зародившееся в далеком прошлом лечебное использование мумие вошло в обиход и удержалось до настоящего времени в народной медицине Центральной Азии, Ирака, Афганистана, Тибета, Индии.
Мумие (его синонимы в отечественной литературе - "горный бальзам", "горная сила", и др.), как установлено современными исследователями, представляет собой сложное по своей химической структуре образование, добываемое в некоторых горных районах мира, в частности, в бывшем Советском Союзе. О высокоэффективных лечебных свойствах мумие свидетельствует литература, хранящаяся в библиотеке института востоковедения АН УзССР, управления духовенства Средней Азии, Казахстана, в отделах Востока библиотек Москвы, Ленинграда, Душанбе, Баку. Более 70 лечебников и трактатов содержат богатейший материал о широком использовании древними врачами мумие в качестве средства, усиливающего регенеративные процессы в различных тканях организма, противовоспалительного, антитоксического, общеукрепляющего препарата, а также восстанавливающего пониженную функцию периферических нервных стволов и анализаторных центров головного мозга.
Мумие, пользовавшееся большой популярностью у народов Востока, не привлекло к себе в прошлом особого внимания медицинского мира западной Европы. В Советском Союзе оно нашло как бы второе рождение. Здесь оно стало предметом большого внимания со стороны ученых, поставивших перед собой задачу расшифровки тайн природы мумие.
Первым изучать свойства древнего бальзама в нашей стране начал Шакиров А.М. В результате многочисленных экспериментальных и клинических исследований, он впервые официально рекомендовал препарат мумие как общий неспецифический биостимулятор при лечении переломов костей. С 1961 года мумие разрешено к применению в клинике УзНИИТО, где была установлена высокая активность препарата, выраженная в сокращении сроков заживления переломов у больных.
Мумие - слово греческого происхождения, оно означает "сохраняющий тело". О происхождении мумие существует множество гипотез, однако ни одна из них не получила достаточно полного научного обоснования. Гипотезы разделяются на 2 группы: геогипотезы и биогипотезы. Сторонниками геогипотез являются такие древние авторы, как Бируни, Авиценна, Аби-Байтар.
Мумие - природная смесь органического и неорганического хорошо растворимого в воде вещества, которое образуется в трещинах скал, в пустотах, нишах в виде пленок, корок, наростов черных, темно-коричневых и коричневых салоподобных масс с примесью песка, щебня. Очищенное от примесей и экстрагированное мумие представляет собой однородную массу темно-коричневого цвета, эластичной консистенции, с блестящей поврехностью, своеобразным ароматическим запахом и горьковатым вкусом. Удельный вес 2-2,5; температура плавления 80ºС; рН 0,5% раствора 6,7-7, при хранении повышается до 7,5. При хранении мумие постепенно отвердевает за счет потери влаги. Легко растворяется в воде (1/8), очень мало растворимо в 95% спирте (1/4500) и эфире (1/10000). Водные растворы прозрачные, бурой окраски. В своем составе имеет органическую и неорганическую части и содержит: около 30 макро - и микроэлементов, около 10 различных окисей металлов, силикатные группы двуокиси кремния, фосфорный ангидрид, различные органические вещества и кислоты. Каждая составная часть способна влиять на соответствующие процессы организма и ускорять регенерацию различных тканей. Микроэлементы оказывают существенное влияние на белковый, углеводный, жировой, минеральный обмен, на окислительно-восстановительные процессы, на процессы регенерации, участвуют в процессах размножения и роста, кроветворения и иммуногенеза. Результатом является неспецифическое стимулирующее действие на весь организм, а также местное действие на заживление ран. Стимулирующее действие проявляется и на клеточном уровне, в результате происходит интенсивное деление, увеличение количества клеток, усиление обмена нуклеиновых кислот и общего белка. Благодаря этому, мумие оказывает благоприятное воздействие на течение лучевой болезни, и восстановление состава периферической крови, костного мозга, селезенки.
В результате комплексных исследований в институте геохимии и аналитической химии им. Вернадского выведена единая формула для разных образцов мумие: CaSi [ (K,Na) C4 H10 CH2 O]. Согласно этой химической формуле, горный бальзам представляет собой своеобразный природный минерал со стабильной органической частью молекулы. Ведущие компоненты минеральной части мумие находятся в хорошо растворимой форме [16].
Многочисленные клинические испытания показали, что мумие свойственна очень низкая токсичность, оно не оказывает выраженного влияния на сердечно-сосудистую систему, дыхание, гладкую мускулатуру, не обладает холинолитическими свойствами. Мумие не вызывает новообразований, следовательно, не является канцерогенным веществом. Введение мумие, даже в больших количествах, не влияет на рождаемость и не вызывает развития аномалий или уродств у плода, а также каких-либо изменений со стороны имплантации яйцеклеток и развития эмбриона. При длительном применении мумие никаких побочных явлений со стороны сердца не наблюдается. В то же время, препарат улучшает электрокардиографические показатели и общее состояние, стимулирует функцию сердечной мышцы. Аллергических реакций и случаев анафилактического шока не обнаружено. Противопоказаний к применению препарата не выявлено. При передозировке препарата изредка возможны диспепсические явления. В таких случаях следует уменьшить дозу или временно прекратить прием мумие.
В настоящее время в целом ряде научных медицинских центров ряда стран СНГ с помощью соответствующих методов фармацевтического исследования изучаются и расшифровываются наиболее полно различные стороны действия препарата мумие, экспериментально обосновываются показания к его применению в современной клинической практике. И уже сейчас имеется достаточно обширный экспериментальный и клинический материал, позволяющий рекомендовать мумие для лечения ряда болезней [17].
Проведенный анализ литературных данных по использованию БГ в медицине и фармации показывает, что их можно широко использовать для медицинских и фармацевтических целей. В настоящее время бентонитовые глины применяются в фармации в производстве таблеток, пилюль, порошков и мазей, однако в Казахстане еще не разработаны мази на основе бентонитовых глин.
По литературным данным мумие обладает рядом целебных действий и разработаны лекарственные препараты мумие для внутреннего применения, а мази мумие на липофильных основах неустойчивые.
Таким образом, отсутствие рационального лекарственного препарата мумие для наружного применения определило цели и задачи нашего исследования.
2. Материалы и методы исследования
2.1 Материалы исследования
Мумие представляет собой небольшие образования желто-коричневого или даже черного цвета. Его состав не бывает однородным. В мумие входит до 70 различных веществ. Представляет собой природный материал со слабой органической частью молекулы. Основные компоненты минеральной части мумие находятся в хорошо растворимой форме. Мумие низко токсично. Почти не имеет противопоказаний, не вызывает новообразований. Мумие назначается 1 раз в день утром натощак, в дозе 0,15-0, 20г. Курс лечения 10 дней, после чего рекомендуется сделать перерыв на 5-10 дней, затем лечение можно повторить вновь. Количество курсов колеблется от 3 до 4 [16].
Дозы мумие для детей в возрасте от 3 месяцев до 1 года - 0,01 - 0,02г, до 9 лет - 0,05г, 9-14 лет - 0,1г в день.
При передозировке изредка возникают аллергическая реакция и некоторые диспепсические явления [17].
Глина белая - порошок с желтым или сероватым оттенком, жирный на ощупь. С небольшим количеством воды замешивается в пластическую массу, обладающую специфическим запахом. Растворимость - препарат практически нерастворим в воде и разведенных кислотах. Подлинность сплавляют 1г препарата с 2г безводного карбоната натрия, охлаждают. Сплав обрабатывают горячей водой, при нагревании фильтруют, фильтрат подкисляют разведенной соляной кислотой, выпаривают досуха. Остаток нагревают с разведенной соляной кислотой. Нерастворившийся остаток (кремниевая кислота) отфильтровывают. К фильтрату прибавляют раствор аммиака до щелочной реакции; образуется белый студенистый осадок, нерастворимый в избытке реактива [18].
Глина голубая содержит в себе минеральные соли, микроэлементы, а именно: кремнезем, фосфат, железо, азот и др. Прекрасное противовоспалительное средство. Обладает очищающими свойствами и дезинфицирует кожу. Активизирует кровообращение и усиливает процессы обмена в клетках кожи. Содержание металлов: цинк - 103,1 мг/кг, марганец - 378,01 мг/кг, медь - 20,20 мг/кг, ртуть - 0,2мг/кг, кобальт - 5,45 мг/кг, свинец - 29,51 мг/кг, кадмий - 0,47 мг/кг, железо - 10852,0 мг/кг. рН 4,5-9. Кожно-раздражающее действие отсутствует. Доза на кожу от применения 1кг сырья 807,36. Предел дозы на кожу 50000. Внутрь людям рекомендуется применять по 20-30г за 1 прием, не более 100г в сутки. При желудочно-кишечных заболеваниях (колите, энтерите, пищевых отравлениях) [19].
Вазелин - смесь жидких, полужидких и твердых углеводородов предельного ряда (алканов), которые представляют собой однородную массу без запаха. Структура вазелина составляет трехмерную сетку, образованную твердой фракцией вазелина, которая удерживает вязкие и жидкие углеводороды. Температура плавления вазелина колеблется в пределах 37-50ºС.
Ланолин безводный представляет собой очищенное жироподобное вещество, состоящее из сложных эфиров высокомолекулярных спиртов и кислот и свободных высокомолекулярных спиртов (смеси алифатических, стериновых и тритерпеновых спиртов). Густая вязкая масса буро-желтого цвета, слабого своеобразного запаха. Растворимость. Практически нерастворим в воде, очень трудно растворим в 95% спирте, легко растворим в эфире, хлороформе, ацетоне и бензине. При растирании с водой препарат поглощает около 150% воды без потери мазеобразной консистенции. Подлинность.0,1г препарата растворяют в 5мл хлороформа и осторожно расслаивают в пробирке на 5мл концентрированной серной кислотой. На месте соприкосновения жидкостей постепенно образуется яркое буро-красное кольцо (холестерин). Температура плавления 36-42ºС [18].
Глицерин . СН2 ОН-СНОН-СН2 ОН (М. в.92.1). Густая, прозрачная, бесцветная, гигроскопичная жидкость, смешивающаяся с водой. Показатель преломления 1.4710-1.4744. Остаток после прокаливания 0,002%. Хлоридов не более 0,002%. Тяжелых металлов не более 0,0005%. Мышьяка не более 0,0002%.
2 г препарата смешивают с 10мл воды, полученный раствор остается бесцветным от прибавления 1 капли раствора фенолфталеина и окрашивается в желтый цвет от 1 капли раствора метилового красного [18].
Агар (агар-агар). Продукт, получаемый из красных морских водорослей. Пористые пластины, толщиной не более 20мм или пленки толщиной не более 0,5мм белого или светло-желтого цвета, допускается слегка сероватый оттенок.
Должен быть без посторонних примесей и включений, плесени и признаков микробиологической порчи. Сухой агар, а также 0,85% студень не должен иметь постороннего запаха и вкуса.
Студень, содержащий 0,85% абсолютно сухого агара, в слое не более 10мм должен быть прозрачным и бесцветным. Допускается опалесценция без окраски.
Температура застудневания раствора агара, содержащего 0,85% абсолютно сухого агара, не ниже 30ºС.
Температура плавления студня, содержащего 0,85% абсолютно сухого агара, не ниже 80ºС.
Прочность студня (в граммах), содержащего 0,85% абсолютно сухого агара, не менее 300.
Падение прочности после нагревания в течение 2 часов раствора, содержащего 0,85% абсолютно сухого агара, не более 10%.
Влаги не более 18%. Золы не более 4,5%. Азотистых веществ (N∙6.25) не более 1%. Йода, мышьяка, солей тяжелых металлов (свинец, цинк и олово) не должно быть. Веществ, нерастворимых в горячей воде, не более 0,3%. Веществ, растворимых в воде комнатной температуры, не более 10% [18].
Судан III . С22 Н16 N4 O (М. в.352,40). Коричневый порошок с зеленым металлическим блеском. Нерастворим в воде, растворим в хлороформе, ледяной уксусной кислоте, трудно растворим в спирте, эфире, эфирных маслах [18].
Бромкрезоловый пурпурный (Бром-о-крезолсульфофталеин). C21 H16 Br2 O5 SМ. в.540,2.
Белый или желтовато-розовый мелкокристаллический порошок. Мало растворим в воде, растворим в спирте, растворах едких и углекислых щелочей и растворе аммиака.
Переход окраски от бледно-желтого к пурпурно-фиолетовой, в пределах рН 5,2-6,8.
Растворы индикатора.1.0,1г растертого индикатора растворяют в 20мл теплого спирта и доводят водой до 100мл.2.0,1г индикатора растирают в ступке с 3,7мл 0,05н. раствора едкого натра и после его растворения доводят свежий прокипяченный и охлажденный водой до 250мл [18].
Бромтимоловый синий (дибромтимолсульфофталеин). C27 H28 Br2 O5 S.М. в.624,4.
Белый мелкокристаллический порошок. Очень мало растворим в воде, легко - в спирте, эфире, растворах едких и углекислых щелочей и растворе аммиака.
Переход окраски от желтой через зеленую в синюю, в пределах рН 6,0-7,6.
Растворы индикатора.1.0,1г растертого индикатора растворяют в 20мл теплого спирта и после охлаждения доводят водой до 100мл.2.0,1г индикатора растирают в ступке с 3,2мл 0,05н раствора едкого натра и после его растворения доводят свежепрокипяченной и охлажденной водой до 250мл [18].
Метиловый оранжевый (4-диметиламиноазобензол-4’-сульфонат натрия). C14 H14 N3 NaO3 S.М. в.327,34.
Кристаллический порошок оранжевого, иногда с коричневым оттенком цвета. Трудно растворим в воде, легче растворим в горячей воде, практически нерастворим в спирте.
Переход окраски от красной через оранжевую к желтой в пределах рН 3,0-4,4.
Растворы индикатора.0,1г растертого индикатора растворяют в воде и доводят водой до 100мл.
Насыщенный раствор индикатора в ацетоне. К 0,025г индикатора прибавляют 100мл ацетона и время от времени встряхивают, через час фильтруют [18].
Фенолфталеин .
Переход окраски от бесцветной к красной в пределах рН 8,2-10,0. Раствор индикатора 1г индикатора растворяют в спирте и доводят спиртом до 100мл [18].
Вода дистиллированная . Н2 О.М. в.18,02.
Бесцветная прозрачная жидкость без запаха и вкуса. рН от 5,0 до 6,8. Кислотность и щелочность. К 10мл воды прибавляют 1 каплю раствора метилового красного; появляется желтое окрашивание, переходящее в розовое от прибавления не более 0,05мл 0,01н раствора соляной кислоты. Сухой остаток.100мл выпаривают досуха и сушат при 100-105ºС до постоянного веса. Остаток не должен превышать 0,001%.
Хранение. В асептических условиях, в доверху заполненных флаконах, не более 24 часов [18].
2.2 Методы исследования
Приготовление геля и агаровых пластинок
Агаровый гель готовится 2% концентрации в предварительно тарированном стеклянном или эмалированном сосуде, плотно закрытом крышкой. Изрезанный агар (ГОСТ 6470-53) заливается очищенной водой и оставляется на 30 минут для набухания.
Набухший агар нагревается до кипения, доводится до необходимой массы и к теплому гелю добавляется 5% реактива Эрлиха состава: п-диметиламинобензальдегида 0,5г, кислоты хлористоводородной концентрированной и этанола 95% по 15мл и н-бутанола - 90мл.
Приготовленный таким образом агаровый гель разливается в чашки Петри с горизонтальной поверхностью дна (d=98-100мм, h=20мм), которые выставляются на столе, предварительно выверенном по горизонтальному уровню с помощью ватерпаса. Агар разливается в чашки двумя порциями по 10 и 15мл. После застывания агара (первой порции) на ее поверхность, в каждую чашку помещаются три металлических цилиндра (из нержавеющей стали или стекла с наружным диаметром 8мм и высотой до 10мм), и заливается второй слой агара. После застывания агара цилиндрики осторожно вынимаются. И в образовавшиеся углубления (колодцы) помещаются исследуемые образцы мази [20].
Определение скорости высвобождения лекарственных веществ из мази
Мази, содержащие лекарственное вещество с различной степенью дисперсности, помещают в лунки двух чашек с агаром. Чашки нумеруют или указывают степень измельчения. Мазь в лунки переносят с помощью стеклянной палочки, осуществляя контроль за тем, чтобы был хороший контакт с агаром. Мази с плотной или вязкой консистенцией перед использованием следует тщательно растирать или выдержать 30 минут при температуре 30ºС. Чашки помещают в термостат с температурой 37ºС.
Лекарственное вещество высвобождается из мази, диффундирует в агаровый гель, образуя с реактивом окрашенную зону. Через 1-2-3 часа, с помощью линейки (лучше - штангенциркуля) измеряют диаметр окрашенной зоны. В случае необходимости (при образовании эллипса) измеряют больший и меньший диаметр, и определяют среднее значение диаметра окрашенной зоны. Полученные результаты записывают в дневник и подвергают математико-статистической обработке.
Средняя ошибка среднего арифметического вычисляется по формуле
m= ±∑аk,
где:
m - средняя ошибка среднего арифметического диаметров окрашенных зон;
∑ - сумма;
а - цифровые значения отклонений диаметров зон от среднего арифметического со знаком "+" или "-";
k- величина, зависящая от числа вариантов, то есть количества опытов (n) для каждого образца мази. В данном случае равна 0,29004 при n=3 [20].
Определение стабильности
Для проверки стабильности и качества мази использовался метод расслаивания - центрифугирование.
На электронных весах отвешивается по 5г мази с каждой модели, помещая их в пробирки. Пробирки устанавливаем в держатели центрифуги.
На первом этапе таймер центрифуги устанавливается на 10 минут на скорость вращения - 500 об/мин. Через 10 минут вынимаем пробирки и, при достаточном освещении, проверяем мази на расслаивание. В случае изменения однородности мазей - разделения их на отдельные компоненты - производят измерение высоты расслоившихся фракций и описание их по внешнему виду.
На втором этапе таймер устанавливается на 10 минут, а скорость вращения центрифуги - 1000 об/мин. По истечении времени проводят те же действия: замеры, определения, что и на первом этапе. На последующих этапах увеличивают только число оборотов. 2000, 3000 об/мин и т.д. Число оборотов увеличивают до тех пор, пока не произойдет расслаивание во всех взятых мазях. По результатам данного опыта мы можем судить о сравнительной стабильности или нестабильности мазей.
Приготовление индикаторов
Фенолфталеин.1г индикатора растворяют в спирте и доводят спиртом до 200мл [18].
Метилоранж.0,1г растертого индикатора растворяют в воде и доводят водой до 200мл [18].
Бромкрезоловый пурпуровый.1.0,1г растертого индикатора растворяют в 20мл теплого спирта и доводят водой до 100мл.2.0,1г индикатора растирают в ступке с 3,7мл 0,05н. раствора едкого натра и после его растворения доводят свежий прокипяченный и охлажденный водой до 250мл [18].
Бромтимоловый синий.1.0,1г растертого индикатора растворяют в 20мл теплого спирта и после охлаждения доводят водой до 100мл.2.0,1г индикатора растирают в ступке с 3,2мл 0,05н раствора едкого натра и после его растворения доводят свежепрокипяченной и охлажденной водой до 250мл [18].
Судан III.0,1г индикатора растворяем в аммиаке и доводим до 100мл 95% спиртом [18].
Агар (агар-агар).2г агара заливаем 98мл холодной воды, оставляем на 30 минут (для набухания). В течение 15 минут выдерживаем на водяной бане, при температуре около 100ºС. Затем заливаем в чашки Петри и оставляем до полного застывания [18].
3. Технология мазей мумие на основе бентонитовой глины
3.1 Разработка состава мазей мумие на основе бентонитовой глины
Первым этапом работы стал подбор оптимального состава мази мумие на основе бентонитовой глины. Нами были предложены шесть моделей мазей мумие на основе бентонитовой глины. Состав моделей в таблице 1.
Таблица 1 Состав модели мазей мумие на основе бентонитовой глины
№ |
Наименование ингредиентов | Номера моделей | |||||
| 1 | 2 | 3 | 4 | 5 | 6 | ||
| Состав, в% | |||||||
| 1 | Мумиё | 7,5 | 7,5 | 7,5 | 7,5 | 7,5 | 7,5 |
| 2 | Вода | 27 | 7 | 7 | 27 | 7 | 7 |
| 3 | Ланолин | 1,1 | 1,1 | 1,1 | 1,1 | 1,1 | 1,1 |
| 4 | Вазелин | 40,5 | 60,4 | 60,4 | 40,4 | 52,4 | 52,4 |
| 5 | Глина белая | 24 | 24 | - | - | 24 | - |
| 6 | Глина голубая | - | - | 24 | 24 | - | 24 |
| 7 | Глицерин | - | - | - | - | 5 | 5 |
Приготовление мазей мумие на основе бентонитовой глины осуществлялось следующим образом: мумие растворяли в воде.
Приготовление основы. Отдельно готовили сплав ланолина и вазелина, затем в сплав добавляли глину при активном перемешивании. При приготовлении моделей № 5 и 6 глицерин добавляли в сплав вазелина и ланолина до добавления глины.
В приготовленную основу частями добавляли раствор мумие в воде.
Выбор состава мази мумиё из предложенных моделей производили по биологической доступности мумиё из моделей мази
Определение биологической доступности полученных моделей мазей мумие на основе бентонитовой глины, по методике описанной в пункте 2.2
В качестве индикаторов использовались слабые растворы судана III, фенолфталеина, метилоранжа, бромкрезолового пурпурового, бромтимолового синего. У судана III, фенолфталеина и бромтимолового синего при взаимодействии с небольшим количеством мумие окраска не изменилась, метилоранж при взаимодействии с мумие помутнел, а бромкрезолово-пурпуровый резко изменил окраску, с грязно-желтого на кроваво-красный.
Таким образом, для определения биологической доступности мази мумие целесообразно использовать бромкрезолово пурпуровый, так как при добавлении его в агар мы получаем четкую картину дифузии мумие в агар (рис.2), нежели при использовании метилоранжа (рис.3).

Рисунок 2 - Диффузия мумие из мази на основе бентонитовой глины в агар-агар с индикатором бромкрезолово-пурпуровым
Рисунок 3 - Диффузия мумие мази на основе бентонитовой глины в агар-агар с индикатором метилоранжем
Результаты исследований биологической доступности мази мумие представлены в таблице 2.
Таблица 2 Высвобождение действующего вещества из лекарственной формы
Модель мази время в мин. |
1 | 2 | 3 | 4 | 5 | 6 |
| 30 | 1 - 12 мм 2 - 14 мм 3 - 13 мм |
1 - 7 мм 2 - 7 мм 3 - 7 мм |
1 - 7 мм 2 - 7 мм 3 - 7 мм |
1 - 11 мм 2 - 12 мм 3 - 12 мм |
1 - 9 мм 2 - 9 мм 3 - 10 мм |
1 - 9 мм 2 - 9 мм 3 - 8 мм |
| 60 | 1 - 15 мм 2 - 16 мм 3 - 15 мм |
1 - 7 мм 2 - 7 мм 3 - 7 мм |
1 - 7 мм 2 - 7 мм 3 - 7 мм |
1 - 12 мм 2 - 12 мм 3 - 12 мм |
1 - 11 мм 2 - 10 мм 3 - 10 мм |
1 - 11 мм 2 - 11 мм 3 - 9 мм |
| 120 | 1 - 23 мм 2 - 20 мм 3 - 21 мм |
1 - 7 мм 2 - 7 мм 3 - 7 мм |
1 - 7 мм 2 - 7 мм 3 - 7 мм |
1 - 18 мм 2 - 20 мм 3 - 20 мм |
1 - 12 мм 2 - 11 мм 3 - 10 мм |
1 - 12 мм 2 - 12 мм 3 - 10 мм |
| 180 | 1 - 23 мм 2-22,5мм 3 - 22 мм |
1 - 7мм 2 - 7 мм 3 - 7 мм |
1 - 7 мм 2 - 7 мм 3 - 7 мм |
1 - 23 мм 2 - 24 мм 3 - 23 мм |
1 - 15 мм 2 - 15 мм 3 - 13 мм |
1 - 16 мм 2 - 15 мм 3 - 14 мм |
Анализируя данные таблицы 2 можно сделать вывод, что действующее вещество не высвобождается из моделей 2 и 3, где в состав основы входит глицерин, тогда как в остальных моделях происходит высвобождение действующего вещества. На рисунках 4 и 5 представлены результаты исследования высвобождения действующего вещества из мазей 2 и 3 по истечении 3 часов. В связи с этим использование такой основы не целесообразно и производить дальнейшие исследования этих двух моделей бесперспективно.
модель мази 2

Рисунок 4 - Результат исследования биологической доступности мази мумие с добавкой глицерина к бентонитовой основе (модель 2)
модель мази 3

Рисунок 5 - Результат исследования биологической доступности мази мумие с добавкой глицерина к бентонитовой основе (модель 3) На рисунках 6, 7, 8, 9 представлены результаты исследования биологической доступности мазей мумие моделей 1, 4, 5, 6.

По оставшимся четырем моделям мази проводили статистическую обработку, трех параллельно проведенных опытов, с учетом средней ошибке среднего арифметического, вычисляемого по формуле
М= ![]()
аК
К - величина, зависящая от числа вариантов (при п=3-0,29004).
Затем определяется среднее арифметическое (м) диаметров окрашенных зон трех параллельно проведенных опытов (мм)
М=
=13,
а отклонение (а) данных каждого опыта от среднего арифметического (+1; - 1; 0). Цифровые значения отклонений (а) от среднего арифметического со знаком (+) и (-) суммируются, не обращая внимание на алгебраические знаки
а =2.
Пользуясь формулой
М= ![]()
аК.
Вычисляют среднюю ошибку среднего арифметического
М =
(2*0,29004) = 0,58.
Таким образом, окрашенная зона исследуемого образца мази (1) через 30 мин ровна 13
0,58 мм. Аналогично обработаны все полученные данные и средние ошибки среднего арифметического диаметра для удобства использования занесены в таблицу 3.
Таблица 3 Средняя ошибка среднего арифметического
Модель мази Время в мин. |
1 | 4 | 5 | 6 |
| 30 | ||||
| 60 | ||||
| 120 | ||||
| 180 |
По полученным данным была построена зависимость
По средне арифметическим показателям, окрашенных зон исследуемых образцов мазей, был составлен рисунок 10.

Рисунок 10. - Динамика высвобождения мумиё в агар
График динамики высвобождения мумие в агар подтверждает отсутствие высвобождения мумие из мази в моделях № 2 и 3, поэтому для дальнейшего выбора состава мази мумиё из моделей No 1, 4, 5 и 6 мы определяем стабильность мази на расслаивание по методике описанной в пункте 2.2
Результаты исследования приведены в таблице 4 и на рисунке 11
Таблица 4 Расслаивание моделей мазей мумиё на основе бентонитовой глины при центрефугировании
Модель мази об/мин. |
1 |
4 |
5 |
6 |
| 500 | Изменений нет | Изменений нет | Изменений нет | Изменений нет |
| 1000 | Изменений нет | Изменений нет | 1,5 мм | 1 мм |
| 2000 | Изменений нет | 2,5 мм | 3,5 мм | 13 мм |
| 3000 | 3 мм | 5 мм | 12 мм | 17 мм |
| 4000 | 4 мм | 7 мм | 15 мм | 19 мм |

Рисунок 11 - Динамика расслаивания мази мумие на основе бентонитовой глины
По данным таблицы 4 и графического рисунка 11 видно что наибольшей стабильностью обладает 1 модель мази мумие на основе бентонитовой глины так как ее расслаивание началось на более высоких оборотах, и в меньшей степени в отличии от других моделей мази. Наглядно разницу между моделями, мази мумие на основе бентонитовой глины, после проведения исследования на стабильность, при 4-тысячах оборотов в минуту, можно увидеть на рисунке 12.

6 модель 5 модель 4 модель 1 модель
Рисунок 12 - Результаты исследования стабильности мази мумиё на бентонитовой основе (модели 1,4,5 и 6)
Таким образом, нами выбран состав мази мумиё на бентонитовой глине с условным названием " Бенто М " (ВentoM). Представленный в таблице 5.
Таблица 5 состав мази мумиё на бентонитовой глине " Бенто М "
(ВentoM)
| Наименование ингредиентов | ||||
| Мумиё в% | Ланолин в% | Вода в% | Вазелин в% | Глина белая в% |
| 7,5 | 1,1 | 27 | 40,5 | 24 |
3.2 Технология мази "Бенто М"
Рациональная технологическая схема производства мази имеет следующий вид. Технологическая схема представлена на рисунке 13.
Стадии технологического процесса:
ВР 1 Подготовка сырья.
ТП 1 Получение мази мумиё на основе бентонитовой глины.
УМО 1 Фасовка мази мумиё на основе бентонитовой глины.
ВР 1 Подготовка сырья
ВР 1.1 Взвешивание мумиё. Для приготовления мази мумиё на основе бентонитовой глины отвешивают на весах мумиё.
ВР 1.2 Взвешивание воды. Для приготовления мази мумиё на основе бентонитовой глины отвешивают на весах воды.
ВР 1.3 Взвешивание вазелина. Для приготовления мази мумиё на основе бентонитовой глины отвешивают на весах вазелин.
ВР 1.4 Взвешивание ланолина. Для приготовления мази мумиё на основе бентонитовой глины отвешивают на весах ланолин.
ВР 1.5 Взвешивание белой глины производят на весах.
ТП 1 Получение мази мумиё на основе бентонитовой глины
ТП 1.1 Приготовление основы. В мазевых котлах, с наружной и внутренней паровой рубашкой, сплавляют вазелин с ланолином.
ТП 1.2 Растворение мумиё в воде. В котел с наружной паровой рубашкой и мешалкой помещают необходимое количество вода. Доводят до температуры 60-70о С и прибавляют мумиё. Перемешивают до полного растворения мумиё.
![]()
![]()

Рисунок 13 - Технологическая схема производства мази мумиё на основе бентонитовой глины
ТП 1.3 Добавление к основе раствора мумиё и белой глины. Горячий расплав переливают в смеситель, добавляют раствор мумиё, белую глину и тщательно перемешивают в течение 5-10 минут. Отбирают пробу для анализа в лаборатории контрольно - аналитических работ и стандартизации препаратов на соответствие требованиям, соответствующим нормам. Готовая продукция представляет собой мазь серо-коричневого цвета, со специфическим запахом мумиё и ланолина.
УМО 1 Фасовка мази мумиё на основе бентонитовой глины
УМО 1.1 Подготовка фасовочной тары.
Освобожденные от упаковочного материала банки из стекломассы ополаскивают снаружи и внутри проточной водопроводной водой для удаления механических загрязнений, затем замачивают в дезинфицирующем 3% растворе пероксида водорода с 0,5% раствором моющего средства, подогретом до температуры (50±10) ˚С в течение 15 минут.
После замачивания банки моют в этом же растворе с помощью ерша, затем ополаскивают не менее 5-7 раз в проточной водопроводной воде при температуре (50-60) ˚С и окончательно промывают водой очищенной. Контроль качества вымытой посуды проводят визуально по отсутствию посторонних включений и по равномерности стекания воды со стенок флаконов после их ополаскивания.
Полноту смываемости моющих средств определяют, ополаскивая испытуемую вымытую банку водой очищенной (банка заполняется водой полностью). Промывной водой смачивают ватный тампон, наносят на него 1 - 2 капли спиртового раствора фенолфталеина. Наличие остатков моющих средств даёт розовое окрашивание, которое должно отсутствовать.
Банки стерилизуют при температуре 180±10 ˚С в течение 60 ± 5 минут.
После снижения температуры в стерилизаторе до 60-70 ˚С банки вынимают и тотчас закрывают стерильными крышками. Срок сохранения стерильности изделий в бумаге упаковочной - трое суток, без упаковки используют непосредственно после стерилизации.
Пластмассовые навинчивающиеся крышки обрабатывают следующим образом: несколько раз промывают в горячей 50 ± 10˚С водопроводной водой и сушат в сушильном шкафу при температуре 50 - 60 ˚С.
Полиэтиленовые крышки обрабатывают следующим образом: несколько раз промывают горячей (50 ±10) ˚С водопроводной водой, затем ополаскивают водой очищенной и стерилизуют погружением свежеприготовленный 6% раствор пероксида водорода на 6 часов, после чего промывают водой очищенной и сушат в сушильном шкафу при температуре 50 - 60 ˚С.
Высушенные крышки хранят в закрытых биксах или стерильных банках с притертыми пробками не более трёх суток.
Мазь расфасовывают в банки из стекломассы с винтовой горловиной типа БВ-30-28-ОС по ОСТ 64-2-71-80, с навинчиваемыми пластмассовыми крышками типа 1.1-28 по ОСТ 64-2-87-81 и прокладками типа 2.1-28 по ОСТ 64-2-87-81 или прокладками картонными уплотнительными с двусторонним полиэтиленовым покрытием по ТУ 64-2-269-78.
УМО 1.2 Маркировка мази. На каждую банку наклеивают этикетку из бумаги этикеточной по ГОСТ 7625-86 Е или писчей по ГОСТ 18510-87 Е.
УМО 1.3 Упаковка банок в пачке. Каждую банку вместе с листком вкладышем на государственном и русском языках помещают в пачку из картона коробочного марки А по ГОСТ 7933-89 Е.
На этикетке и пачке указывают название страны - производителя, название предприятия-изготовителя, его товарный знак, адрес, название препарата на латинском, государственном и русском языках, содержание действующего вещества в процентах, количество препарата в граммах, состав, условия хранения, регистрационный номер, номер серии, срок годности, условия отпуска, предупредительные надписи "беречь от детей", "не применять по истечении срока годности". Осуществляют контроль фасовки.
Заключение
Республика Казахстан располагает большими ресурсами природного лекарственного сырья: минералов (бентонит, мумие, каменная поваренная соль), сырье животного (яды змей и пчел) и растительного происхождения. Кроме того, научно-исследовательскими институтами страны синтезируются десятки новых биологически активных веществ.
Мумие известно в восточной медицине более 3000 лет. Его применяли в своей практике средневековые ученые Востока - Ибн Сино, Бируни, Рози, Мухаммед Табиб, Мухаммед Арзани и многие другие. Однако, оно стало объектом исследования современной медицины только в последние 35-45 лет (Шакиров, 1967, 1983; Нуралиев Ю.Н., 1977, 1993; Корчубеков Б.К., 1993; Фролова Л.Н., 1999).
Бентонитовые глины в фармацевтической технологии применяются при производстве мазей, таблеток, в качестве адсорбента для очистки белков, ферментов, а также для стабилизации суспензий и ряда физиологически активных субстанций, таких как простагландины и фосфолипиды (Сало Д.П. и др., 1969г), (Цагарейшвили Г.В., 1974 г.; Кариев А.Р., 2001г).
Несмотря на проведенные многочисленные исследования вышеуказанных объектов, до сих пор, отсутствуют рациональные лекарственные формы на их основе.
Поэтому, разработка высокоэффективных и недорогостоящих лекарственных форм на основе бентонита, мумие, является одной из актуальных проблем современной фармацевтической науки.
Проведенный анализ литературных данных по использованию БГ в медицине и фармации показывает, что их можно широко использовать для медицинских и фармацевтических целей. В настоящее время бентонитовые глины применяются в фармации в производстве таблеток, пилюль, порошков и мазей, однако в Казахстане еще не разработаны мази на основе бентонитовых глин.
По литературным данным мумие обладает рядом целебных действий и разработаны лекарственные препараты мумие для внутреннего применения, а мази мумие на липофильных основах неустойчивые.
Таким образом, отсутствие рационального лекарственного препарата мумие для наружного применения определило цели и задачи нашего исследования.
Разработанная нами мазь мумиё на основе бентонитовой глины, для лечения ран и ожогов, при изготовлении которой учитывались факторы, влияющие на стабильность и эффективность мази, такие как взаимодействие входящих ингредиентов, концентрация действующего вещества, оказалось выгодной благодаря наличию отечественного сырья и относительно доступной цене. Следовательно мазь может заменить аналоги, импорт которых осуществляется из-за рубежа.
После проведенных исследований мы можем сделать выводы:
1. Разработаны составы моделей мази мумие на основе бентонитовой глины.
2. Методом диффузии в агар установлено, что основа (24% глины белой, 1,1% ланолина, 27% воды, 40,5% вазелина) является наиболее приемлемой для достижения желаемого терапевтического эффекта мази мумие.
3. Методом расслаивания - центрифугированием - установлено, что модель мази на основе (24% глины белой, 1,1% ланолина, 27% воды, 40,5% вазелина) наиболее стабильна среди исследованных в эксперименте.
4. В результате проведенных исследований установлен оптимальный состав мази мумие на основе бентонитовой глины, с условным названием " Бенто М "
5. Разработана технология и технологическая схема производства
Список использованных источников
1. Чуешов В.И. Промышленная технология лекарств. - Харьков. - 2002. - с.443
2. www.Jandex. kz
3. ”Фармацевтическая технология. Технология лекарственных форм." Уч. для студентов высш. учеб. заведений под ред.И. И. Краснюка, Г.В. Михайловой, - 2 изд. Москва 2006-с.448
4. Энциклопедия лекарств. Регистр лекарственных средств России. Изд 7/Под ред. Ю.Ф. Крылова. - Москва: РЛС-2000, 2000 г. - 1519 с.
5. Бентонитовые глины Узбекистана. Изд-во УзбССР, Ташкент, 1963 г. 196 с.
6. Martindale. The Extra Pharmacopoea, thirty-first edition. London, Royal Pharmacal society, 1996, pages 1536 2-1831 2.
7. Тихонов А.И., Доденидзе И, А., Авденен А.Д., Холупян И.Ю. Разработка состава и исследование защитных паст с гидрофобным фенольным препаратом прополиса на бентонитовой основе. Фармацевтический журнал, Киев 1991 г., №2, с.68 - 72.
8. Дильбарханов Р.Д., Сакипов З.Б. и др. Изучение антимикробной активности многокомпонентной мази с левомицетином на основе бентанитовой глины Республика Казахстан. Фармацевтический бюллетень. - Алматы, 1999 № 4 - с.20
9. Сихимбаева Л.М. Разработка состава и технологии 5% - стрептоцидовой мази в композиции с метронидазолом. Фармацевтический бюллетень. - Алматы, 1999 № 12 - с.16
10. Исупов С.Д., Сатторов С., Салимов Т.М. Изучения антимикробной активности мази фурацилина на основе бентонитовых глин Таджикистан. Кыргызская Государственная медицинская академия. Лекарство и здоровье населения. Сборник научных трудов, посвященный 75-летию Заслуженного деятеля науки Кыргызской республики, доктора медицинских наук, профессора Марии Токтогуловны Нанаевой. Бишкек 2002, - с.220 - 224
11. Исупов С.Д., Сатторов С.С., Дильбарханов Р.Д. Антимикробная активность мази стрептоцида на основе бентонитовых глин Таджикистан. Журнал Медицина и Экология № 1, 2003 г., - с.47 - 48
12. Затурецкий Л. Объем и границы применения бентонитов в технологии лекарственных препаратов. В книге << Бентонитовые глины Чехословакии и Украины >> Киев1966 г., - с.146 - 153
13. Лехан А.С., Сало Д.П., Башура Г.С. - Фарм., Ж., 1969 г., - с.3 - 45
14. Лехан А.С., Сало Д.П. Тезисы докладов юбилейной научно-практической конференции Харьковщины, посвященной 50-летию Великого Октября, Харьковввв, 1967 г., - с.25
15. Халифаев Д.Р., Ходжиматов М.Х. Гил ва гилдавои (глина и глинолечение). Душанбе 2002 г., 163 с.
16. Мельник А.В. Чудо-целитель на все времена. М.: РИПОЛ классик, 2005. - 64 с.
17. www.Google.ru
18. ГФ X часть II
19. www.Google.ru
20. Методические указания по спецкурсу “Биофармация” Харьков 1986 - 152 с.
Похожие рефераты:
Методы анализа лекарственных препаратов
Принципи підбору основ для м'яких лікарських форм
Мази в промышленном производстве
Вспомогательные вещества в технологии лекарственных форм
Бентонит как природный наноматериал
Технология гетерогенных и комбинированных мазей
Современные методы фармацевтического анализа
Разработка состава и технологии получения мази, содержащей биокомплекс кобальта с фуразолидоном
Технология ветеринарных лекарственных форм для инъекций
Лекарственные вещества, их свойства и анализ
История развития технологии лекарственных форм
Закономерности размещения, условия формирования, типизация и пронз ресурсов мумие в Горном Алтае
